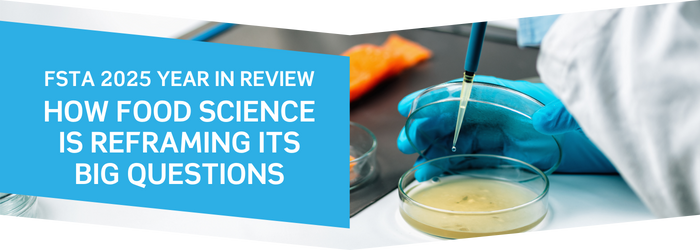
FSTA 2025 Year in Review: How Food Science is Reframing its Big Questions

Welcome to the January edition of the IFIS newsletter! We are kicking off 2026 with our highlights of new features, tips, resources, and much more.
Let's dive into the latest news you won't want to miss >>>

As we enter 2026, the field of food science continues to evolve rapidly. Our latest annual report draws on keyword descriptor trends from 2024 and 2025 to explore how food science is evolving and what those shifts mean for researchers working at the intersection of food, health, and technology.
From gut health and functional foods to sustainability and food safety, the latest FSTA trends show a shift toward systems thinking, biological realism, and real-world application. See where the centre of gravity in food research is moving – and why it matters for your next project or product.
Claim your free copy of the FSTA 2025 Year in Review report

When literature searching, do not overlook a key source for scientific information: patents!
Most academic food and nutrition research is published in scholarly journals, but industry research is often shared once intellectual property is protected through patents. University researchers may also patent their methods and technologies.
Ignoring the insights contained within patents will mean that you are missing out on relevant information. Find out more about finding and retrieving patents

Every month, we review the latest entries vetted by the FSTA science team for their quality, integrity, and relevance. As 2026 begins, it's an ideal moment to reflect on the high-quality records that have been added to FSTA over the past year.
Over 200,000 new records were added to FSTA in 2025, including journal articles, patents, reviews, and more from across the world. These new records were collected from 1,992 sources, including 435 publishers based in 69 countries.
During 2025, we expanded our diverse range of sources further, with 36 new journal titles and patents from 6 additional countries included in the live list being monitored for relevant content.
Learn more about the newest additions, screened by the FSTA science team for quality, integrity and relevance.

 |
AI as Your Ally: Ethical and Effective Ways to Use AI in Academic Research and Writing
AI can help with tasks such as generating ideas, structuring content, synthesising literature, and more. But maintaining ethical usage is key. Read more |
 |
PODCAST | Future of Food: Innovations in Health and Sustainability
We review research trends from 2024 including transformative food technologies, gut health, and plant-based foods. Read more |
 |
Why Food Security Should Mean More Than the Bare Minimum
Exploring why food security must encompass more than just production, focusing on nutrition, equity, and resilience for a sustainable future. Read more
|
.png?width=1400&height=150&upscale=true&name=Newsletter%20headings%20SLIM%20(700%20x%2075%20px).png)

.png?width=1400&height=150&upscale=true&name=Newsletter%20headings%20SLIM%20(700%20x%2075%20px).png)
